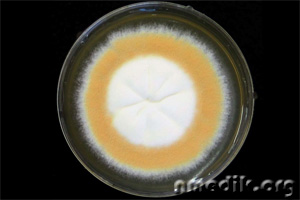
image

Существуют разные виды грибковых заболеваний. Они отличаются друг от друга типом возбудителя инфекции, клиническими симптомами, локализацией и тяжестью протекания. Патогенный грибок поражает собой кожные покровы и ногтевые пластины. После инфицирования человека начинают беспокоить признаки недомогания, которые считаются первым проявлением болезни. Если не приступить к лечению на этой стадии развития микоза, то он продолжит распространяться на другие части тела.
Что такое микозы кожи и ногтей
Грибок относится к числу самых распространенных дерматологических заболеваний, от которых страдают и взрослые, и маленькие дети. Заражение инфекционным возбудителем в большинстве случаев происходит во время непосредственного контакта с местом, где находятся его споры. Грибы свободно проникают в кожу через микроскопические ссадины и открытые ранки.
Возбудитель микоза может проникнуть в организм здорового человека через гематогенный путь. В данном случае винить в заражении следует поражение внутреннего органа хроническим очагом грибковой инфекции.
При обнаружении признаков грибковых болезней требуется немедленно обратиться за профессиональной медицинской помощью. Лечение микозов, независимо от их классификации, нужно проводить под строгим контролем врача.
Разновидности грибкового поражения по Шеклакову
Микоз кожи и онихомикоз вызывают патогенные грибки, которые проникают в организм человека. Также подобные заболевания нередко развиваются из-за того, что иммунная система человека теряет способность сдерживать активность условно-патогенных грибов, присутствующих в естественной микрофлоре.
Выделяют разные виды грибка у людей. Их классифицируют по глубине проникновения инфекции, площади поражения и локализации патологического процесса. Таким образом, существуют следующие группы микозов:
- Кератомикозы;
- Дерматомикозы;
- Кандидамикозы;
- Глубокие микозы;
- Псевдомикозы.
Современная медицина не может предложить пациентам с микозом универсальное лекарство, которое способно справиться с любыми проявлениями грибка кожи и ногтей. Для каждого случая подбирается индивидуальное лечение, действие которого направлено на подавление активности и размножения конкретного патогена.
Классификация по Шеклакову группирует микозы по глубине и локализации поражения, вне зависимости от типа возбудителя
Кератомикозы
Классификация грибковых заболеваний кожи содержит такой вид, как кератомикозы. Они вызываются грибками, которые пагубно отражаются только на роговом и поверхностном слоях кожи, а также затрагивают кутикулу волос. При течении подобных инфекций отсутствует воспаление в глубоких слоях эпидермиса.
Специалисты разделяют группу кератомикозов на несколько видов. К ней относятся такие патологии:
- Белый лишай;
- Черный лишай;
- Черепицеобразный микоз;
- Тропический желтый и белый лишай;
- Отрубевидный лишай;
- Узловатая трихоспория.
Заболевание возникает из-за повышенной активности плесневых, дрожжеподобных грибов и дерматофитов. Всего существует около 70 различных патогенов, которые приводят к развитию кератомикозов.
Лечение грибковой инфекции этого типа заключается в купировании причины ее развития. К примеру, при диагностировании разноцветного лишая пациенту предлагается терапия, действие которой направлено на устранение эндокринных нарушений и повышенной потливости.
Чтобы удалить дефекты, которые остаются после микоза, больным рекомендуют пройти лечение ультрафиолетом.
Отрубевидный лишай, как и другие представители группы, поражает роговой слой эпидермиса
Дерматомикозы
Возбудители дерматомикозов глубоко проникают в слои эпидермиса, поэтому избавиться от них без специального лечения практически невозможно. Они приводят к развитию следующих патологий:
Все эти разновидности дерматомикозов являются заразными. Данные грибковые заболевания вызывают деформацию той части тела, которая оказалась ими поражена. Чаще всего страдают стопы и кисти рук. Еще одними характерными симптомами заболевания является изменение структуры волос и их выпадение, а также рубцевание кожного покрова.
Идеальной средой для размножения грибка являются места с повышенным уровнем влажности. Вот почему ими часто поражаются стопы, которые постоянно потеют. Первоначально инфекция поражает собой межпальцевое пространство и ногти. После она перебирается на здоровые участки кожи. Запущенная болезнь может распространяться на большие территории.
Если пациент вовремя обратился с дерматомикозами в больницу, то ему удастся ограничиться стандартным лечением местного вида. Чтобы уничтожить патогенную микрофлору, достаточно будет регулярно обрабатывать пораженные участки тела специальными противогрибковыми препаратами для наружного применения.
При запущенных формах патологического процесса потребуется прием более серьезных препаратов в виде таблеток, которые помогают бороться с грибком изнутри.
Кандидамикозы
При трихофитии человек лишается волос
Обусловленные дрожжеподобными грибами
Дрожжевой грибок обнаруживают и у мужчин, и у женщин. Он без труда поддается лечению, если оно было правильно подобрано конкретному пациенту. Очень важно начать борьбу с инфекционным возбудителем на ранней стадии его развития, так как в запущенной форме он приводит к появлению неприятных осложнений.
Определить эти виды дрожжеподобных грибковых инфекций у человека может только врач. Для этого ему нужно ознакомиться с результатами анализов, которые были пройдены больным.
Заподозрить у себя развитие инфекции, которая вызывается дрожжеподобным патогеном, помогают определенные симптомы:
- Ощущение зуда и жжения в пораженной области;
- Высыпания разного типа;
- Появление белых выделений на слизистых оболочках;
- Апатия и хроническая усталость;
- Покраснение;
- Отечность мягких тканей;
- Болезненные ощущения в области расположения живота;
- Болезненность при половом акте и процессе мочеиспускания;
- Повышенное потоотделение;
- Расстройства психики.
Грибковая инфекция этого типа передается разными способами. А именно через пищу, предметы, во время полового акта, а также через воздушно-капельный путь. Так что в целях профилактики требуется держатся подальше от людей, которые заражены кандидозом.
Специалисты выделяют несколько типов заболеваний, которые вызываются дрожжеподобными грибами:
- Кандидоз внутренних органов. Его еще принято называть висцеральным. При таком течении болезни поражается пищеварительный тракт, половые органы и дыхательная система. Также могут пострадать мочевыводящие пути;
- Поверхностный кандидоз. Его диагностируют при поражении ногтевых пластин и кожного покрова тела;
- Кандидоз слизистых оболочек. При данной патологии обнаруживается стоматит или молочница.
Дрожжеподобный грибок нередко обнаруживается в области паха, подмышек и лица. Для его подавления достаточно пройти грамотное лечение.
Кандидоз поразил горло больного
Вызванные плесневыми грибками
Плесневые грибы находятся в организме каждого человека в малом количестве. Как правило, они не приносят никакого вреда и дискомфорта, пока рост патогенов контролирует иммунная система. В противном случае наблюдается их активное развитие. Довольно часто к такому исходу приводит долгий прием антибиотиков.
Плесневым микозом принято называть несколько видов заболеваний. Его возбудители имеют сложную классификацию с огромным количеством отличий. Самым часто встречаемым микозом является аспергиллез. Не менее распространенными считаются мукормикоз, пенициллиоз и цефалоспориоз. Список плесневых патологий можно продолжать очень долго, так как он достаточно большой.
Плесневые грибы можно обнаружить практически в любом месте, где бывает человек. Их несложно найти в почве, деревьях, фруктах и даже пыли, которая попадает в дыхательные пути. Патогены способны обитать на кожном покрове и слизистой оболочке живых существ. Стоит более детально ознакомиться с основными видами заболеваний, к которым приводят плесневые грибы.
Как уже говорилось ранее, чаще всего люди заражаются аспергиллезом. К нему приводит грибковый патоген, который способен вызвать заболевание легких, не поддающееся терапии. Обнаружить грибок можно на обычных подушках, которые находятся в каждом доме.
Инфекционное заболевание обнаруживается у людей и птиц. Менее ему подвержены животные. Возбудитель грибковой патологии при наличии благоприятных условий ведет активную жизнедеятельность на слизистых оболочках, кожном покрове и внутренних органах. При развитии аспергиллеза у человека появляются жалобы на следующие признаки недомогания:
- Сухой кашель;
- Отдышка;
- Вялость;
- Хрипы в грудной клетке.
Заражение патогеном, который приводит к появлению данного заболевания, происходит во время его вдыхания с воздухом. Также он проникает в организм человека через желудочно-кишечный тракт, попадая туда вместе с едой.
Следующим заболеванием, которое вызывается плесневыми грибами, является цефалоспориоз. К его развитию приводят более 70 видов патогенов этого типа. Грибы обитают в огромном количестве в окружающей среде. При заражении ими у человека возникают признаки пустулезного, везикулезного или экземоподобного высыпания. При тяжелом течение заболевание поражает структуру внутренних органов.
Цефалоспориоз с трудом поддается диагностике. Ее удается обнаружить лишь после прохождения нескольких лабораторных мероприятий.
Не менее распространенным заболеванием является мукормикоз. При такой патологии плесневые грибы поражают дыхательные пути. Первыми от патологического процесса страдают придаточные пазухи и нос. Патогенная микрофлоры также может нарушить целостную структуру пищеварительной системы и легких.
Плесневые грибы, которые приводят к развитию мукормикоза, попадают в организм человека через органы дыхательной системы или поврежденные участки кожи. Первый вариант является более распространенным. При отсутствии сильного иммунитета из-за болезни пациент страдает от лихорадки.
При лечении грибковых заболеваний самое главное подобрать те лекарственные препараты, к которым патогены достаточно чувствительны. В противном случае терапия не принесет никакого результата.
Из всего многообразия грибов в заболеваниях человека особую роль играют грибы класса Imperfecta. Класс грибов, которые составляют различные виды в зависимости от преимущественной среды обитания, подразделяют на:
- геофильные, обитающие на земле и растениях;
- зоофильные, обитающие у различных животных;
- антропофильные, обитающие у человека;
- зооантропофильные, имеющие среду обитания как на различных животных, так и у человека.
Попадая в человеческий организм, грибы поражают кожу, слизистые оболочки и внутренние органы. Болезнетворными являются как сапрофитирующие грибы (условно патогенные для человека), так и патогенные, которые, попадая в организм из окружающей среды, размножаются и вызывают заболевание.
Для того чтобы у человека возникло грибковое заболевание, необходимо наличие нескольких факторов. К ним относятся:
- ослабленная иммунная система;
- заболевания эндокринной системы;
- нарушение функции тканей, являющихся барьером между окружающей и внутренней средой организма;
- повышенная температура внешней среды;
- повышенная влажность внешней среды;
- наличие микроорганизма.
Классификация грибковых заболеваний кожи
Грибковые заболевания классифицируются по глубине проникновения грибов и расположению болезнетворного процесса:
1. Кератомикозы
Кератомикозы, располагающиеся в поверхностных слоях эпидермиса, роговом слое или кутикуле волоса. При этом полностью отсутствуют воспалительные явления. К кератомикозам относятся:
- разноцветный лишай;
- узловатая трихоспория.
В эту группу заболеваний входят нозологические единицы, возбудители которых внедряются в поверхностные слои кожи и волос, не вызывая поражения ногтей. Воспалительные явления отсутствуют.
Разноцветный лишай
Возбудителем является Malassezia furfur. Причинами внедрения этих грибов становятся повышенная потливость и изменение рН потожировой мантии, которые зависят от условий окружающей среды, т. е. от повышенной температуры, влажности. Кроме этого, причины паразитирования грибов зависят от наличия у человека эндокринных и хронических заболеваний, вегето-сосудистой дистонии, а также от несоблюдения гигиенического режима.
При разноцветном лишае на светлой коже появляется пятно цвета кофе с молоком, на темной коже – пятно белесоватого цвета.
Лечение разноцветного лишая предполагает прежде всего соблюдение личной гигиены (правильного использования мыла, устранения раздражения кожи, использования слабокислых растворов для протирания кожи). Помимо этого, необходимо вовремя выявлять и лечить заболевания, приводящие к гипергидрозу и изменению состава пота.
Для наружного лечения применяют: лечение по Демьяновичу, т. е. однократно обрабатывают очаги поражения раствором № 1 и № 2. Также используют спирты с кератолитическими средствами, жидкость Андриасяна.
Узловатая трихоспория
Узловатая трихоспория, или Пьедра, объединяет две клинические формы:
- Белая Пьедра представляет собой эндемическое заболевание, распространенное в Южной Америке, встречается в ряде стран Европы. Возбудитель этого заболевания – Trichosporum beigelii. При данной болезни характерно образование узелков на волосах (колонии гриба) головы, усов, бороды, лобка.
- Черная Пьедра – заболевание, чаще всего возникающее в тропических районах с высокой влажностью.
Возбудителем является Trichosporum hortai Brumpt. Образовываются характерные узелки на волосах головы.
Лечение узловатой трихоспории заключается в бритье и стрижке пораженных волос, мытье горячей водой с мылом, содержащем серу (сульсеновое мыло).
2. Дерматофитии
Дерматофитии, которые располагаются в более глубоких слоях кожи, дают развитие воспалительных явлений, могут поражать даже придатки кожи. К ним относятся:
- эпидермофития;
- руброфития;
- трихофития;
- микроспория;
- парша, или фавус.
В данную группу микозов включают заболевания, поражающие эпидермис, дерму, придатки кожи (волосы, ногти).
Причиной поражений являются грибы трех родов, которые, в свою очередь, подразделяются на множество видов и подвидов:
- род Trichophyton (содержит 17 видов);
- род Microsporum – 10 видов;
- род Epidermophyton – единственный вид.
Читайте также: Как похудеть при поликистозе яичников
Ранее причиной кожных грибковых заболеваний было принято считать определенный вид или подвид гриба. В настоящее время имеются более совершенные методы определения видов грибов и стали очевидными следующие правила:
- Различные грибы могут провоцировать единообразную патологическую картину.
- Один и тот же вид гриба может провоцировать различную клиническую картину.
- Как внешне, так и внутренне различные грибы могут иметь схожий внешний вид.
- Грибы единого вида могут иметь различный внешний вид.
Дерматофитии могут сопровождаться аллергическими реакциями. Возникающие аллергиды называют микидами. Они располагаются на расстоянии от очага кожного поражения, вызванного грибами, но сами не содержат грибов.
- лихеноидные;
- пятнисто-папулезные;
- дисгидрозиоформные;
- по типу нодулярной эритемы.
Эпидермофития
Эпидермофития имеет две разновидности:
- эпидермофития стоп, в которой различают три формы: сквазно-гипёркератолитическую, интертригинозную, дисгидротическую;
- паховая эпидермофития.
Лечение эпидермофитии предполагает:
- десенсибилизирующую терапию (препараты кальция);
- противовоспалительную терапию (примочки с различными лечебными растворами, жидкость Бурова);
- местные фунгицидные средства;
- кератолитические мази типа мази Уайтфильда после содовых ванночек.
Руброфития
Руброфития, вызываемая Trichophyton rubrum, протекает более тяжело по сравнению с эпидермофитией. Имеются следующие формы руброфитии:
- руброфития стоп;
- руброфития кистей и стоп;
- генерализованная руброфития;
- руброфития ногтей.
Лечение рубромикоза заключается в следующем:
- отслойка кожи (если процесс на гладкой коже) с помощью лака;
- назначение гризеофульвина по схеме;
- витаминотерапия (витамин А длительными курсами);
- использование иммуномодуляторов;
- аутогемотерапия.
Трихофития
Трихофития – микоз, поражающий гладкую кожу, волосы и ногти. Бывает две формы трихофитии:
В первом случае заболевание вызывается антропофильными грибами. У детей часто наблюдается хроническая форма, которая у мальчиков с наступлением половой зрелости может исчезнуть сама собой.
Глубокая форма (инфильтративно-нагноительная) вызывается зооантропофильными грибами.
Заболевание характеризуется более глубоким поражением кожи с развитием инфильтративных бляшек, в центре которых происходит нагноение и разрушение волосяных фолликулов, чего не бывает при поверхностной форме трихофитии. Ногти в процесс не вовлекаются. При надавливании на такую бляшку с боков из пораженных фолликулов начинает выделяться гной. Эта форма трихофитии чаще всего возникает у жителей сельской местности, потому что они постоянно контактируют с домашними животными, сеном, где паразитируют вышеупомянутые грибы.
Глубокая форма трихофитии подразделяется на еще несколько разновидностей:
- инфильтративно-нагноительная трихофития лица;
- инфильтративно-нагноительная трихофития волосистой части головы;
- инфильтративно-нагноительная трихофития гладкой кожи.
Лечение заключается в следующем:
- гризеофульвин по схеме;
- антисептические влажно-высыхающие повязки из 5-10%-ного ихтиола, раствора жидкости Бурова;
- смазывание 5%-ной настойкой йода;
- эпиляция волос (ручная).
Микроспория
Микроспория – высокотоксичное грибковое заболевание, вызываемое антропофильными и зоофильными видами Microsporum. Грибы поражают волосы и гладкую кожу.
Данное заболевание подразделяется на два вида:
- Микроспория зооантроиофильная. Клинические признаки заключаются в образовании инфильтрованных отечных бляшек с четкими границами, выраженными явлениями воспаления и покрытые серебристо-белыми чешуйками.
- Микроспория антропофильная. Клиническими признаками являются эритематозные кольцевидные очаги поражения кожи. Волосы обламываются постепенно и высоко. Обломки волос окружены своеобразными «муфточками» из спор гриба. Чаще поражается гладкая кожа с вовлечением в процесс пушкового волоса.
Парша
Парша – грибковое заболевание, поражающее волосистую часть головы, гладкую кожу, ногти и внутренние органы.
Парша подразделяется на три разновидности поражения кожи:
- Скутулярная типичная (на эритематозно-инфнльтративном фоне – скутулы, волосы тусклые, безжизненные, ломкие, имеется специфический мышиный запах; на месте высыпаний образуются рубцы).
- Сквамозная (питириоидная) атипичная (эритематозные шелушащиеся участки кожи, похожие на себореиды, волосы истонченные, тусклые; имеются явления рубцовой атрофии).
- Импетигинозная (скутулы, имеются фолликулярные узелки, желтоватые корки, напоминает вульгарное импетиго). Кроме того, имеются аллергиды (фавиды) – гнойнички. Все это напоминает поражение волос лихеноидного характера. Поражение ногтевых пластин – развитие скутул в толще ногтя, а в последующем – образование подногтевого гиперкератоза.
Поражение внутренних органов происходит по тину пневмонии, менингита, поражения костей, желудочно-кишечного тракта.
3. Кандидоз
Кандидоз располагается на коже, слизистых, придатках кожи – ногтях, а также внутренних органах.
Кандидозы – заболевания, вызываемые дрожжеподобными грибами рода Candida на фоне ослабления иммунитета, причинами чего становятся заболевания желудочно-кишечного тракта, эндокринные нарушения, заболевания крови, гиповитаминозы, вегетативно-сосудистая дистония и пр. Кроме того, нарушение личной гигиены, происходящее в условиях повышенной температуры и влажности, меняет рН мантии кожи, приводит к развитию кандидоза.
Патологические проявления можно разделить на три группы:
- поверхностный кандидоз;
- хронический генерализованный кандидоз;
- висцеральный кандидоз.
Лечение кандидоза предполагает:
- выявление и лечение заболеваний, приводящих к серьезным нарушениям иммунитета;
- прекращение введения антибиотиков, глюкокортикоидов и других иммуносупрессоров;
- правильный уход за кожей;
- диету, содержащую кисло-молочные продукты, а также продукты с большим содержанием витаминов группы В;
- десенсибилизирующую терапию;
- комплексную иммунотерапию.
Для усиленного лечения необходимо провести несколько перемежающихся курсов, т. к. наружное лечение зависит от остроты процесса и его расположения.
При островоспалительных проявлениях используют примочки с лекарственными растворами, анилиновыми красителями, жидкостью Кастеллани и др.
Кроме того, рекомендуются к использованию кремы и мази, содержащие нистатин, леворин, декамин и др.
При поражении слизистых оболочек назначают карамели, содержащие декамин, леворин. Вагинально применяют:
- вдувание порошков (нистатин, леворин);
- спринцевания;
- тампоны с раствором буры в глицерине (20%-ный раствор на 6-8 ч);
- местное использование таблеток, мазей, содержащих нистатин, леворин.
Для удаления ногтей назначают наружно уреапласт. После содовой ванночки препарат накладывают на 48 ч, защитив здоровую кожу. После этого повторяют содовую ванночку и счищают размягченную часть ногтя.
Эту операцию следует повторять до полного удаления ногтевой пластинки. После отрастания ногтя его ложе смазывают анилиновыми красителями, мазями, содержащими леворин, нистатин.
4. Глубокие микозы
Глубокие микозы, располагающиеся в собственно коже и подлежащих тканях, внутренних органах с явлениями воспаления:
- бластомикоз;
- споротрихоз;
- хромомикоз;
- мадуромикоз;
- кокцидиомикоз;
- гистоплазмоз;
- риноспоридиоз.
Глубокие микозы – системные грибковые заболевания, при которых поражаются кожа, слизистые и внутренние органы на фоне эндокринных нарушений, белковой недостаточности и пр.
Бластомикоз
Самым основным заболеванием данной группы является бластомикоз, в котором имеется три клинические формы:
- европейский бластомикоз, или болезнь Буссе-Бушке. Это заболевание встречается только в Европе. Характерно появлением узелков в коже и паренхиматозных органах. Кроме этого, могут возникать симптомы, напоминающие менингит;
- североамериканский бластомикоз, или болезнь Джил-крайста. Заболевание распространено в Канаде, США, странах Африки, отдельные случаи встречались в Европе. Характеризуется поражением легких, кожи и костей, в которых образуются гранулематозные поражения. Подкожные узлы вскрываются, образуя язвы, покрытые корками;
- южноамериканский бластомикоз, или паракокцидиодоз, болезнь Лютца-Сплендора-Альмейды. Заболевание, распространенное в Мексике, Центральной и Южной Америке, характеризуется поражением кожи, слизистых, регионарных лимфоузлов и внутренних органов. Поражает в основном жителей сельской местности, занимающихся земледелием.
Лечение заключается в следующем:
- назначение сульфаниламидов быстрого и продолжительного действия в течение 2 лет. Данная терапия, как правило, дает хорошие результаты;
- при обширных поражениях и в упорных случаях показано применение амфотерицина В внутривенно в растворе 5%-ного раствора декстрозы (вводить лучше в подключичную вену);
- рекомендуются иммуномодуляторы (левамизол), пи-рогенные вещества;
- назначение аутогемотерапии.
Псевдомикозы
В эту группу заболеваний входят те, которые раньше относили к различным группам грибковых заболеваний. В настоящее время установлена принадлежность возбудителей некоторых заболеваний к другим классам микроорганизмов.
5. Коринобактериозы
Эритразма
Эритразма – встречается во всех регионах земного шара. Заболевание характеризуется проявлением пятна н паховых складках красно-бурого цвета или гиперпигментированного с белесоватым налетом на темной коже, которое представляет собой огромную колонию микроорганизмов. Как правило, такие проявления особенно не беспокоят больного, но при раздражениях кожи могут принимать вид экземы. Заболевание возникает на фоне повышенной потливости, изменения рН потожировой мантии вследствие нерационального гигиенического режима и нарушений в эндокринной системе.
Подмышечный трихомикоз
Подмышечный трихомикоз, или надкрыльцовый трихонокардиоз, нокардиоз. Заболевание характеризуется изменением внешнего вида волос в различных впадинах тела и на лобке, цвета пота, который содержит колонии вышеуказанных микроорганизмов. Пораженные волосы не обламываются, внешний вид изменяется за счет заселения кутикулы волоса колониями микроорганизмов. Волосы приобретают желтый или буровато-коричневый цвет. Подмышечный трихомикоз возникает у лиц с повышенным потоотделением, обусловленным вегетативно-сосудистой дистонией или обменно-эндокринными нарушениями при контакте с инфицированными предметами.
Актиномикоз
Актиномикоз, или псевдоглубокий микоз, возбудителем являются представители грамотрицательных бактерий. Заболевание, встречающееся в любом регионе земного шара, характеризуется появлением узлов типа гранулем в мышцах, лимфоузлах. Впоследствии эти узлы выходят на поверхность кожи, где их отделяемое вызывает раздражение кожи и ее воспаление. Кроме того, могут поражаться легкие и желудочно-кишечный тракт.
Актиномикоз подразделяется на три вида:
- шейно-лицевой с образованием подкожных узлов и их последующим выходом на поверхность кожи;
- торакальный (легочный), когда происходят изменения в легких по типу туберкулезных с вовлечением в процесс ребер;
- абдоминальный – напоминает хронический аппендицит, карциному с дальнейшим выходом узелков на переднюю стенку живота.
- соблюдение рационального гигиенического режима;
- выявление и лечение обменных и эндокринных нарушений;
- наружную терапию;
- выявление и лечение астенизирующих заболеваний;
- повторное бритье волос в пораженных зонах, смазывание кожи в указанных местах 1%-ным раствором йода, 3%-ным раствором салицилового спирта;
- назначение актинолизата в инъекциях внутримышечно, начиная с 0,3-0,5 мл, постепенно повышая дозу до 3,0-4,0 мл 2-3 раза в неделю (20-25 инъекций на курс);
- инъекции высоких доз пенициллина (используют до 50 млн ЕД в сутки на курс до 30-45 дней);
- использование препаратов тетрациклинового ряда – 2,0 г в сутки в течение 6-8 недель;
- назначение антибиотиков-цефалоспоринов;
- назначение антибиотиков-макролидов;
- использование сульфаниламидов;
- хирургическое иссечение измененных тканей;
- промывание пораженных полостей дезинфицирующими растворами;
- аутогемотерапию.
- Потница у детей и взрослых
Читайте также: Осмотр у уролога у мужчин
Человеческий организм населяет множество вирусов, грибков и бактерий. Все эти микроорганизмы могут быть полезными, условно-патогенными, либо патогенными. При этом два последних вида не приносят вреда до тех пор, пока между микроорганизмами соблюдается определенный баланс
Грибковая инфекция
Человеческий организм населяет множество вирусов, грибков и бактерий. Все эти микроорганизмы могут быть полезными, условно-патогенными, либо патогенными. При этом два последних вида не приносят вреда до тех пор, пока между микроорганизмами соблюдается определенный баланс.
Наибольшую опасность представляет грибок – микроорганизм, который способен приводит к поражению кожных покровов и внутренних органов человека. Существует порядка 500 видов грибков, вызывающих у человека микоз. Какие грибковые инфекции способны вызывать серьезные заболевания у людей, и какие способы лечения применяются для избавления от патогенных микроорганизмов?
Виды грибков
Все грибки, способные обитать в организме человека, делятся на несколько видов:
Грибы — многоклеточные
Дрожжевые грибки обитают в человеческом организме, являясь частью его микрофлоры. Они относятся к условно-патогенным видам, так как не представляют угрозы здоровью при условии соблюдения баланса.
Все остальные виды грибков являются патогенными и представляют реальную угрозу здоровью и жизни людей.
Грибки могут размножаться как на поверхности кожных покровов и ногтях, так и внутри организма. Однако здоровый человек, как правило, не поражается грибковой инфекцией, так как ее уничтожают клетки иммунной системы. Поэтому наиболее благоприятные условия для жизнедеятельности грибка созданы в организме людей с ослабленным иммунитетом.
Особенности микоза кожи
Кожные покровы очень часто страдают от грибковой инфекции. Причем она не щадит ни женщин, ни мужчин, ни детей.
Данное заболевание разделяется на несколько основных групп:
Эпидермофития – это заболевание грибковой природы, вызываемое грибами рода эпидермофитонов. Наиболее часто им страдают мужчины. При эпидермофитии поражается не только верхний слой кожи, но и ногти.
Существует две формы этого заболевания:
Дерматомикозы – это целая группа грибковых инфекций кожи, от которой страдает каждый пятый человек планеты. При этом микоз может развиваться не только на кожных покровах, но и во внутренних органах. Становясь носителем грибка, человек заражает людей, входящих в его близкое окружение, как правило, членов своей семьи. Наиболее подвержены заражению люди с ослабленной иммунной системой, в том числе старики и дети.
Споротрихоз – это хроническое грибковое заболевание, вызываемое грибами рода Sporotrichium. Заражение происходит через контакт с травой, кустарниками, землей, уличной пылью и даже пищевыми продуктами. При этом чаще всего поражается кожа и подкожная клетчатка. Слизистые оболочки и внутренние органы подвергаются воздействию грибка очень редко.
Кандидоз вызывается дрожжевыми грибами рода Candida. Данные микроорганизмы входят в состав здоровой микрофлоры и выполняют важные функции в организме человека. Однако при создании благоприятных условий грибы Кандида начинают активно размножаться, нарушая баланс бактерий, что приводит к развитию кандидоза. Чаще всего кандидоз или молочница появляется во влагалище у женщин и в ротовой полости у детей. Но при отсутствии лечения может распространяться на внутренние органы, в том числе кишечник, вызывая тяжелую форму дисбактериоза.
Трихофития – это грибковое заболевание, называемое стригущим лишаем. Чаще всего им страдают дети, контактирующие с бездомными животными. Стригущий лишай поражает всю поверхность кожи тела и головы, а также ступни и ногти.
Причины развития грибковой инфекции
Развитию грибковой инфекции способствует контакт с источником грибов. Например, их споры могут находиться в воздухе, на поверхности пола или в птичьем помете. При этом для размножения грибкам требуется особая среда, которая создается при снижении защитных функций организма.
Хотя микоз может возникнуть у любого человека, есть определенные группы населения, которые наиболее подвержены развитию данного заболевания.
К ним относятся:
люди, перенесшие операции по пересадке донорских органов;
онкологические больные, а также люди, перенесшие химиотерапию и лучевую терапию;
люди, страдающие сахарным диабетом и легочными заболеваниями.
Грибки могут размножаться на поверхности кожи. Но любимыми местами дислокации являются складки кожи, сгибы рук и ног, то есть все места, где присутствует повышенная влажность и температура тела.
Микоз может распространиться на небольшом участке, например, между пальцами рук или ног. Но некоторые грибки способны поражать глубокие слои ткани. Если же микоз развивается в легких, он попадает в кровоток, что приводит к поражению внутренних органов.
С течением времени состояние больных людей, заразившихся грибковой инфекцией, значительно ухудшается, приводя к необратимым последствиям. При этом грибок, проникший в кровоток, способен привести к сепсису и летальному исходу.
Микоз внутренних органов
Симптомы и лечение грибка в крови зависят от разновидности грибковой инфекции. Наиболее распространенными являются следующие инфекционные заболевания:
висцеральный кандидомикоз (системный кандидоз);
Висцеральный кандидомикоз
Это заболевание, развивающееся вследствие повышения активности грибов Candida Albicans. По сути, это обычная молочница, только место ее локализации отличается от привычных гениталий. При системном кандидозе одновременно поражаются слизистые оболочки ротовой полости и гениталии, а также кожные покровы и внутренние органы человека.
Наиболее восприимчивы к воздействию грибка следующие системы организма:
Признаки болезни
Чаще всего системной форме кандидоза предшествует кандидозный вульвовагинит, баланопостит или грибковый стоматит. При снижении защитных функций организма и отсутствии адекватного лечения данные формы болезни переходят в висцеральную, когда грибок распространяется по организму, приводя к поражению внутренних органов.
О наличии заболевания свидетельствуют следующие признаки:
ухудшение общего самочувствия;
снижение или полная потеря аппетита;
повышение температуры тела, сопровождаемое ознобом;
помутнение сознания и потеря трудоспособности.
Кокцидиомикоз
Данное заболевание вызывается грибами рода Coccidioides imitus, которые обитают в почве. Этот микроорганизм распространен в наиболее засушливых районах Америки, Африки и Мексики. В другие страны он попадает вместе с товарами, поставляемыми из этих стран.
Признаки кокцидиомикоза
Первые симптомы заболевания напоминают ОРВИ и воспалительные процессы в легких и бронхах. На наличие грибка указывают следующие признаки:
незначительное повышение температуры тела;
общая слабость организма.
Позже к этим симптомам присоединяются боль за грудиной, одышка и сухой кашель. Через пару недель после легочных проявлений болезни у больного появляются кожные высыпания в виде папул или узелков, внешне напоминающих бородавки.
Гистоплазмоз
Данный недуг вызывается грибами Histoplasma capsulatum, которые чаще всего поражают легкие. В некоторых случаях грибок распространяется на другие органы, что при отсутствии лечения приводит к смерти больного. Данному заболеванию подвержены люди, страдающие СПИДом, что объясняется уязвимостью их иммунной системы.
Признаки гистоплазмоза
Острая форма заболевания чаще всего протекает бессимптомно, что затрудняет его диагностику и затягивает с началом лечения. При тяжелой форме у больных отмечаются следующие проявления:
повышение температуры тела до 40°-41°С
озноб, сменяющийся сильным потоотделением;
сильные головные и мышечные боли;
боли за грудиной;
При отсутствии лечения болезнь принимает хроническую форму.
Особенности лечения грибковой инфекции
Лечение любой грибковой инфекции предусматривает внутренний прием антимикотических лекарственных средств, а также проведения симптоматической терапии, позволяющей улучшить общее состояние больного. При тяжелых формах заболеваний лекарственные препараты вводятся внутривенно.
Продолжительность курса лечения зависит от вида грибковой инфекции и степени тяжести заболевания. В целом он составляет от 1 до 3 месяцев. Кроме этого больным назначаются лекарственные препараты, укрепляющие иммунную систему организма.
Профилактические мероприятия
Грибок – это коварный микроорганизм, который тяжело поддается уничтожению. Поэтому любую инфекцию легче предупредить. Прежде всего, необходимо укреплять иммунитет, что позволит ему самостоятельно бороться с любыми возбудителями.
Также рекомендуется придерживаться следующих правил:
соблюдать личную гигиену, мыть руки перед едой, после каждого посещения туалета и общественных мест;
тщательно мыть овощи и фрукты;
животная пища должна подвергаться длительной термической обработке;
рационально питаться, сведя до минимума употребление простых углеводов и сахара;
следить за массой тела;
принимать антибактериальные и гормональные препараты только по назначению врача;
при половых актах пользоваться презервативами.
Очень важно, обнаружив несколько признаков грибковой инфекции, обратиться к врачу и пройти полное обследование организма. Это позволит выявить возбудителя на ранней стадии, своевременно начать лечение и избежать более серьезных последствий для здоровья.опубликовано econet.ru.
Остались вопросы — задайте их здесь
P.S. И помните, всего лишь изменяя свое сознание — мы вместе изменяем мир! © econet
Понравилась статья? Тогда поддержи нас, жми:
>



